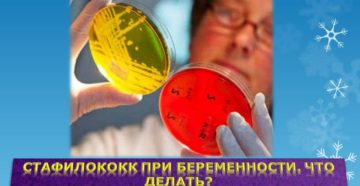
Стафилококк при беременности Стафилококк при беременности

Почему нет месячных в течение месяца при отрицательном тесте Первое, что подозревает женщина при продолжительной…
Рубрика “Гинеколог”
Категория: Гинеколог
Цикловита Уникальным комплексом витаминов и минералов, разработанным специально для женского организма, является Цикловита. Инструкция по…
Стафилококк при беременности в моче, мазке, носу и горле: причины и последствия Стафилококк… Это название…
Причины отрицательного теста при пятидневной задержке С задержкой менструации сталкивались все женщины. Не всегда нарушение…
Причины восьмидневной задержки и отрицательного теста Менструальный цикл в норме длится от 25 до 35…
Список явных причин задержки месячных Менструальный цикл — комплекс изменений в организме женщины, направленных на…
Травмы, удар в живот при беременности на ранних и поздних сроках: последствия Часто беременные женщины…
Когда бежевые выделения требуют лечения В определённых ситуациях светло-бежевый цвет выделений не относится к патологиям…
Почему может болеть клитор и как с этим бороться? Клитор — женский наружный половой орган,…
Причины двухнедельной задержки при отрицательном тесте Задержки менструации могут быть физиологическими или патологическими. Не всегда…